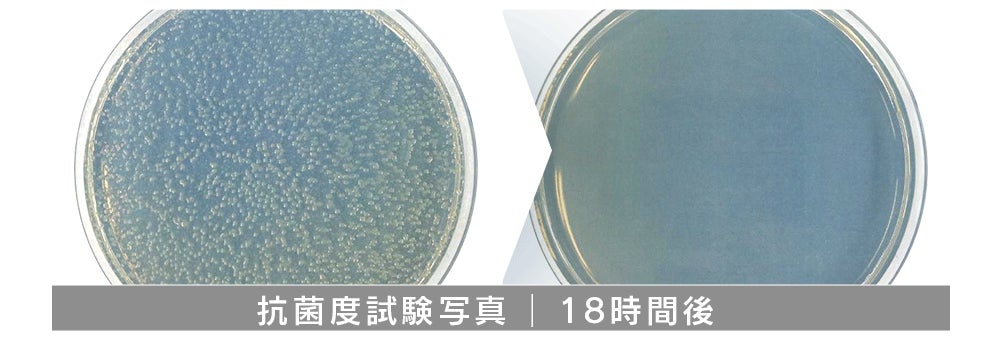

ウイルス対策に花粉対策、
カビ対策にPM2.5対策・・・
外では対策しているけれど、お家の中は?
こんな屋外から帰宅した後、
コートなど上着についたホコリ気になりませんか?
クローゼットの中のカビなどの雑菌気になりませんか?

最近の温床になりやすいクローゼットごと消毒したい!!
そんな衝動にかられませんか?

目次
1. クローゼットメイト開発ストーリー
2. 一度着た服が混ざっているクローゼットの中?
3. クローゼット全体をキレイにしたい!
4. ジメジメした梅雨の時期の湿気対策?
5. クローゼット開けたときに臭い!
6. スマートエアサーキュレーション
7. 抗菌カートリッジ
8. アロマフィルター
9. 交換式抗菌除湿剤バッグ
10. リターン
11. スケジュール
12 製品仕様
13. ご使用にあたってのご注意

ウイルスが洋服に付着してない?
子ども服の除菌大丈夫?
クローゼットの中が湿気っぽい!
ペットの臭いがついてない?
コートに花粉が付着したままなんじゃない?
・・・etc
毎日身につける服は清潔でありたい。
そんな気持ちで開発が始まった「CLOSET MATE」
ウレスジのクローゼット型クリーニング機は、とてもいいモノだけど・・・
値段も高いし、大きすぎて家に置くスペースがない!
それに、結局またクローゼットにしまうわけで、手間がかかります。
除湿機があれば、カビなどの雑菌の繁殖は防げるけど・・・
重くて、大きいし、
脱臭や殺菌まではできません。
除湿ができて、匂いも取ってくれて、殺菌までしてくれたらいいのに!
しかも、クローゼットの中で24時間、365日効き目があったら、サイコー!
「CLOSET MATE」は、こんな風に小さなブレストを重ねて開発していきました。

クローゼットにかけるだけで、安価で、
消臭・除菌・抗菌・除湿・芳香できる商品が完成しました!


>> 一度着た服が混ざっているクローゼットの中?

「スマートエアサーキュレーション方式」で
2時間毎にクローゼット内の空気を全体的に循環させます。

>> クローゼット全体をキレイにしたい!
交換可能な「抗菌カートリッジ」で一度に空気清浄します。

まずは、フリーフィルターで、生活臭や動物の毛、荒いホコリを除去します。
次に、HEPAフィルターで、99.31%以上、空気中の雑菌をろ過します。
最後は、抗菌フィルターで、さまざまな菌の成長を99%以上抑制します。
>> ジメジメした梅雨の時期の湿気対策?

「抗菌除湿剤」で除湿と菌の繁殖も防ぐことが可能です。
>> クローゼット開けたときに臭い!

カートリッジは「アロマフィルター付き」
フランスから直輸入したラグジュアリーな香りを
6種類ご用意しました。

[ スマートエアサーキュレーション方式 ]
特長1.静か
高機能なファンが、密閉された空間を常時循環させます。ファンの音は、20~25dbと大変小さく、他の生活騒音と比べても日常生活では気にならないレベルです。

特長2.かんたんでコンパクトなハンガー式
クローゼットの中で埋もれないように、また衣類の取り出しの邪魔にならないように、ハンガーのデザインにもこだわっています。
ポールのすぐ下に設置されるので、クローゼット内でじゃまになりません。
また、衣類に邪魔されず空気の循環が可能になるので、クローゼット全体をくまなく換気できます。

特長3.かんたんな充電式(Type-C使用)
3時間の充電で約1ヶ月使用可能です。最近のガジェットに多いType-Cの充電ケーブルなので、どこでもかんたんに充電できます。

特長4.タッチでON/OFF
CLOSET MATE丈夫左側にある凹みをタッチするとピーピと音がなり動作開始します。
もう一度タッチすると、ピーという音とともに動作が停止します。

[ 抗菌カートリッジ ]
特長1.かんたんカートリッジタイプ
4層のフィルターがひとまとめになったカートリッジ方式だから、交換もかんたん!

特長2.プレフィルターで有害細菌を99.9%抑制
黄色ブドウ球菌、肺炎菌などの成長をプレフィルターが99.9%抑制します。
服やクローゼットの中に増殖した各種細菌やカビやゾウムシは、健康を脅かす危険があります。
特長3.KF94マスクと同レベルのHEPAフィルター
CLOSET MATEで採用しているPH13のHEPAフィルターは、マイクロ粒子を96.31%以上ろ過します。
PH13からHEPAフィルターと呼ばれますが、マスクのKF94、KF80に該当するグレードです。

特長4.抗菌フィルターでその他の細菌を99.9%除去
抗菌フィルターで、ブドウ球菌、肺炎菌、大腸菌、ラット腸チフス菌(サルモネラ)、緑膿菌の成長を99.9%抑制します。

[ アロマフィルター ]
特長1.フランス直輸入の上品な香り
アロマフィルターは、高級ホテルでも使用されているラグジュアリーな香りのついたフィルターです。ほのかな香りは、3ヶ月持続します。
特長2.6種類の香り
本格的な6種類の香りをお楽しみいただけます。

[ 交換式抗菌除湿剤バッグ ]
特長1.手軽に交換
2~3ヶ月使用可能な抗菌除湿剤バッグです。
製品の下部にあるフックに取り付け、必要に応じて交換して使用できます。

特長2.各種試験済み
CLOSET MATEの除湿剤は、各種試験に合格しています。


リターンについて

スケジュール
・2024年2月:プロジェクト開始
・2024年3月:プロジェクト終了
・2024年4月中旬~:リターンお届け予定
※詳細に関しましては、活動報告等で随時、進捗情報をご報告させて頂きます。
製品仕様
[ 本体 ]
サイズ:253 x 46 x 99 mm
重量:約200 g
材質:ABS、SUS
充電:USB Type-C
電池容量:3000 mAh Li-ion充電池
充電時間:約3時間
連続使用時間:2分作動後1時間停止繰り返し、満充電後1ヶ月持続
[ 抗菌カートリッジ ]
フィルター:H13グレードヘパフィルター
Sensual oud wood
神秘的なスモーキーな香りと特別なオードウツドの出会いに深い繊細さを加えます。
Chic and lime
ライムとバジルの組み合わさった工キソチツクな香りを感じることができます。
My Magnolia
ウッディ香をベースにし、賢沢なゆりの香りと爽やかなシトラスの 調和か深い余韻を残します。
In the sea
爽快な海と爽やかな花の香り。波に寄せられたサンコ礁や砂のような深い余韻を感じます。
For Rest with me
針葉樹林の警蒼とした深い森の中、苔や風を感じられる爽やかな香り。
Lovely Sandalwood
柑橘とベリーの爽やかさ。サンダルウッドをベースに気品を感じられる香り。
ウィルステストレポートNo:2021KRIBS1534.001
バクテリアテストレポートNo:9R98-RF93-9DK8
[ 抗菌除湿バッグ ]
除湿剤120g入
ご使用にあたっての注意
・ 本製品には修理可能な部品はありません。
・ 本製品の除湿剤バッグを破ったり、除湿剤を吸い込んだり分離したりしないでください。
・ 本体を水や液体に浸さないでください。
・ 機器やカートリッジが損傷している場合は使用を中止してください。
・ 火災、爆発、けがを防ぐため、使用前に機器を点検してください。
・ 濡れているときは本製品を使用しないでください。
・ 濡れた手で機器に触れたり操作したりしないでください。
・ 本製品を操作または保管するときは、日の当たるところや火気の近くから離れてください。
・ 可燃性または可燃物から離れて使用してください。
・ 香りカートリッジのフィルターを手で取り除いたり、強制的に取り外さないでください。
・ 香りカートリッジが正しく配置されていることを確認してから使用してください。
・ 抗菌除湿剤が製品下部にあるフックに落ちないよう、しっかり取り付けてください。
・ 抗菌除湿剤のパッケージが破れている場合は使用を中止してください。
・ 抗菌除湿剤をナイフなどで引き裂いて内容物を取り出さないでください。
・ 抗菌除湿剤の内容物をお子様が吸入しないようご注意ください。
・充電する前に、必ず本機の電源を切ってください。
実行者:株式会社AJAX(正規代理店)について
AJAXとかいてアイアスと読ませるという、ひねくれ者が集まった会社です。
2008年AJAXを設立しました。
私たちは、iPhoneの通話レコーダーやスキミング防止バッグ、赤ちゃんの声に反応するIoTなライト、ブラインドを自動化するIoT機器、プログラミングロボットなどオリジナル商品の開発に力を入れています。あったらいいなを皆さんにお届けしたいと日々精進しています。
資金の使い道について
今回みなさまにご支援いただいた資金は、安定供給のための量産化費用、また、次回発売予定の開発資金に当てさせていただきます。
リスク&チャレンジ
※使用感などに関しては、感じ方に個人差が予想される製品でございます。そのため、使用感等に関する返品・返金はお受けいたしかねます。
※初期不良以外に関する返品・返金はお受けいたしかねます。
※開発中の製品につきましては、デザイン・仕様が一部変更になる可能性もございます。
※モニター環境によって、画像の色が実物と異なって見える場合がございます。
※一般発売価格は、状況によって変動する可能性がございます。
※日本国内市場における一般発売は中止となる可能性がございます。
※ご支援後のご支援者様都合によるキャンセルや返金は受付いたしませんのでご了解ください。
※ご注文状況、使用部材の供給状況、製造工程上の都合により出荷時期が遅れる場合があります。
※総販売元として正規流通に努めておりますが、万が一並行輸入品等が発生した場合、責任を負いかねます旨ご了承願います。なお、並行輸入品、個人輸入等、国内の弊社正規品以外のものについては、一切サポートや保証の対象外となります。
※本文中に記載させていただいたスケジュールは、あくまでプロジェクト公開時点の予定です。クラウドファンディングの性質上、配送遅延のおそれがございます。
※原則として、配送遅延に伴うクラウドファンディングのキャンセルはできませんが、リターン配送予定月から6ヶ月を超えた場合には、希望者に限りキャンセルにて対応させていただきます。
特定商取引に基づく表記
事業者名称:株式会社AJAX
所在地:〒990-0065 山形県山形市双月町2-6-3
お問い合わせ先:問い合わせフォーム
なお、ご支援の方法や決済方法等に関しては CAMPFIREヘルプ をご確認ください。
<募集方式について>
本プロジェクトはAll-in方式で実施します。目標金額に満たない場合も、計画を実行し、リターンをお届けします。
最新の活動報告
もっと見る
【進捗報告】無事にプロジェクトが終わりました!
2024/04/01 15:56こんにちは!クローゼットメイト応援隊長です。さて、昨日、無事プロジェクトが終わりました~ご支援いただいた皆さまに感謝です。ありがとうございました。早速、韓国のメーカーに発注したところです。届きましたら、また報告いたします! もっと見る















コメント
もっと見る